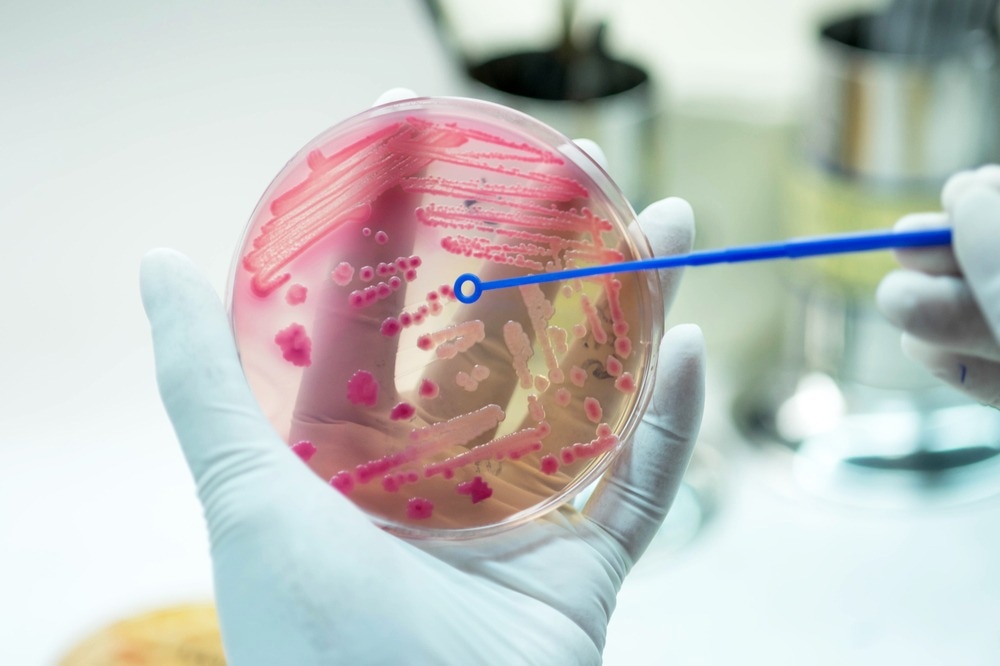
Antimicrobial Resistance

Introduction
The threat of AMR cannot be overestimated
The current landscape of AMR resistance
What's the hold-up?
References
Antimicrobial resistance (AMR) refers to the evolution of strains of bacteria, viruses, protists, or fungi that are no longer susceptible to antimicrobial drugs.
AMR happens naturally over time, but it is dangerously accelerated by the misuse and overuse of antimicrobials, such as inappropriate prescriptions or failure to complete courses of antibiotics.
Image Credit: AnaLysiSStudiO/Shutterstock.com
The threat of AMR cannot be overestimated
Future predictions of AMR are a cause for great concern, and the WHO has declared it as a top ten threat to humanity. Drug-resistant infections were directly responsible for an estimated 1.27 million fatalities in 2019, and this is predicted to surge to over 10 million by 2050 without significant action against AMR.
Drug-resistant diseases carry higher rates of transmission and often prove fatal. This will impact the future safety of even the most standard medical procedures, such as hip replacements and caesareans.
Unfortunately, the regulations surrounding the use of antimicrobials and education on AMR vary around the globe.
Low- and middle-income countries (LMICs) often lack access to a wide range of antimicrobial drugs and are, therefore, disproportionately affected in terms of infection risk and the emergence of drug resistance.
The global threat of AMR is, therefore, directly dependent on international cooperation over the use of antimicrobials. Drug-resistant infections spread rapidly, as seen with the SARS-CoV-2 pandemic, so the protection of current and development of new antimicrobials should be a universal goal.
The current landscape of AMR resistance
Resistance to antibiotics
Since the golden age of natural antibiotics that followed the discovery of penicillin in 1928, the over-reliance and mainstream use of antibiotics have been met with the increasing emergence of strains of drug-resistant bacteria.
For example, the antibiotic ciprofloxacin has seen resistance climb to over 92.9% for Escherichia coli related UTIs. Whereas nearly 60% of global Klebsiella pneumoniae bacterial infections, a common cause of hospital-acquired pneumonia, are reported to be resistant to the last resort antibiotic carbapenem.
Uncertainties over antiviral therapies
Many successful antiviral regimes rely on multi-drug cocktails to lower the probability of developing resistance.
Highly active antiretroviral therapy (HAART) has been the standard treatment for individuals infected with HIV since the mid-’90s; however, varying access and compliance to the expensive 3-4 drug regime could compromise the efficacy of future care.
While there has been much excitement over the development of long-acting intravenous injections for HIV, the extension of these medications to LMICs where the infection burdens are often highest, has not yet been secured.
Antimalarial resistance
Separately, in the struggle against P. falciparum-induced malaria, several countries in the Western Pacific and South-East Asia have reported resistance to the first-line treatment of artemisinin combination therapy.
This news is extremely worrying since malaria is one of the leading causes of child mortality, and its global prevalence is expected to increase due to global warming.

Image Credit: Christoph Burgstedt/Shutterstock.com
What's the hold-up?
Challenges to developing novel antimicrobials
Historically, the most effective antimicrobials have been found in nature as the competition for survival within and between species of microbes incites chemical warfare through the production of toxic secondary metabolites.
However, isolating and characterizing these bioactive compounds is a long and challenging process, further troubled by the risk of compound rediscovery.
When combined with the need to use all antimicrobials sparingly, sourcing investment for the development of new drugs can be difficult. In 2016 less than 5% of US pharmaceutical research investment was tied to the development of new antibiotics, yet global antibiotic consumption had risen over 65% since 2000.
The ever-increasing threat of AMR with the redundancy of so many first and second-generation antimicrobials has ultimately resulted in the need for financial rewards as research incentives.
New places for new cases
In attempts to avoid compound rediscovery, researchers have been going far and wide in the search for undiscovered natural antimicrobials. Isolated environments with extreme physical conditions, such as the deep sea, cryosphere, or isolated underwater caves, are hoped to be home to species producing more chemically diverse compounds.
Alternatively, and slightly closer to home, the antibiotic Legdunin was discovered from within the human nasal cavity. This cyclic peptide antibiotic has successfully demonstrated multi-level protection against S. aureus infections.
The promise of technology
Fitting with the general direction of the 21st century, revolutions in technological capabilities are hoped to overcome many of the challenges facing antimicrobial development.
A great example of this is the discovery of teixobactin through the invention of the iChip. This device recreates a polymicrobial environment for co-culturing microorganisms within a laboratory setting, raising species recovery to 50% while promoting competition to produce a wider range of antimicrobials.
Powerful bioinformatics tools are now able to reconstruct and mine microbial metagenomes to search for biosynthetic gene clusters (BGC) that produce secondary metabolites with alternative chemistries.
This overcomes the barrier of some BGCs remaining silent in culture and facilitates the recombinant cloning of BCGs into hosts that can produce higher product quantities for testing.
Furthermore, CRISPR-Cas9 genetic engineering has been employed to knock out BGCs associated with frequently rediscovered antibiotics in strains of actinomyces. This was shown to encourage the production of rarer antibiotic variants e.g., amoicetin, and thiolactomycin.
Public access to databases such as the Global Natural Product Social Molecular Network (GNPS) also helps avert compound rediscovery and advises the development of natural antimicrobial analogs.
This was seen with the development of the novel antifungal agent nystatin. The generation of semi-synthetic chemical analogs with differential mechanisms of action will be invaluable to battling ongoing resistance.
Sharing and safeguarding future antimicrobials
The sophistication of genetic engineering approaches, next-generation sequencing, and bioinformatics is reawakening interest in natural antimicrobial discovery by increasing the alignment of experimental practices to the high-throughput nature of modern drug research.
While this is a momentous step forward, it must be remembered that global cooperation over access to antimicrobials and protection of their use is fundamental to the fight against AMR.
References:
Further Reading
Last Updated: May 10, 2023